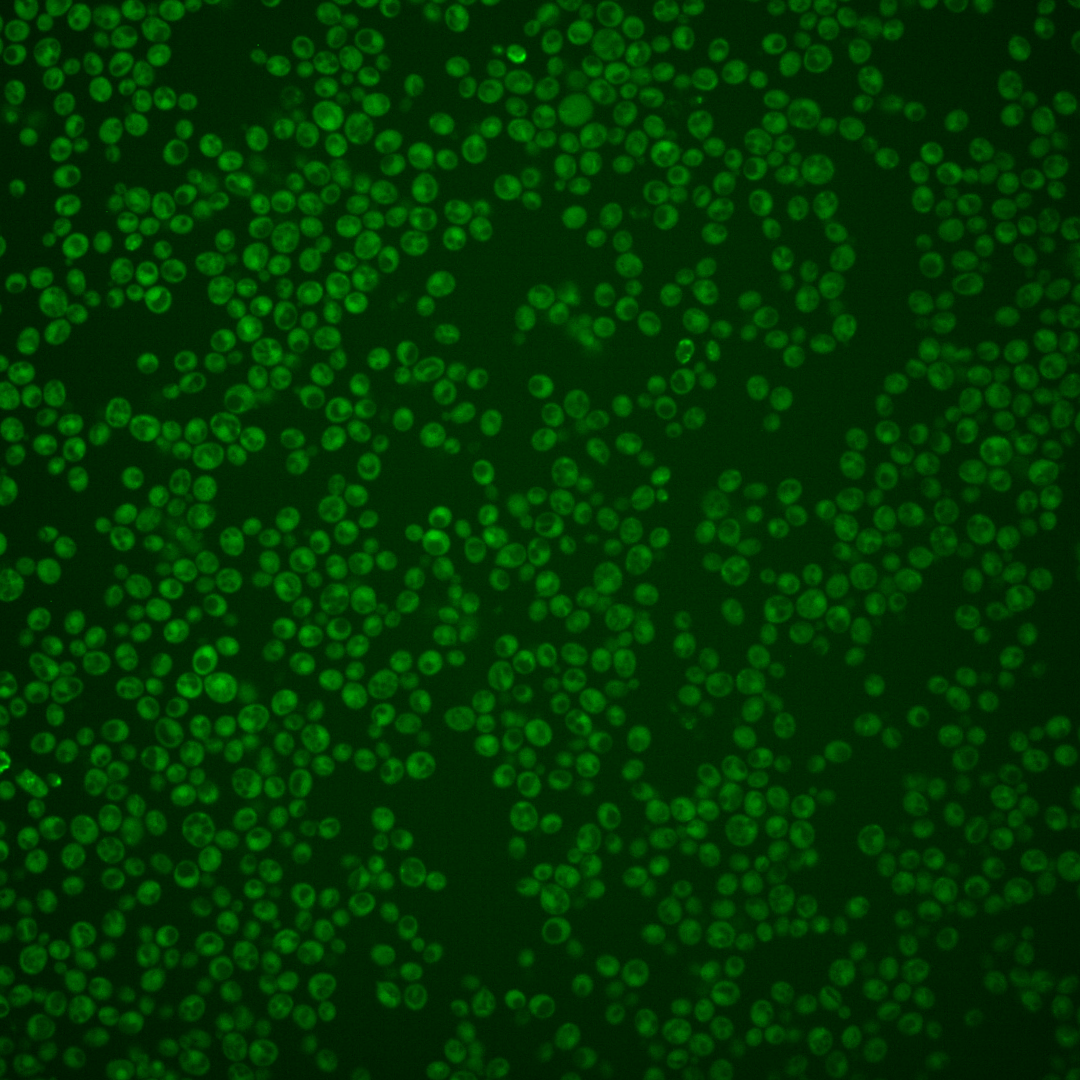

| Standard name | |
|---|---|
| Human Ortholog | |
| Description | Glucosamine-6-phosphate acetyltransferase; evolutionarily conserved; required for multiple cell cycle events including passage through START, DNA synthesis, and mitosis; involved in UDP-N-acetylglucosamine synthesis, forms GlcNAc6P from AcCoA |
Micrographs




















































































Sub-cellular Localization
Yeast GFP Assignment
Protein Abundance
Localization Change
External localization resources
| ensLOC | DeepLoc | |||||||||||||||||||||||
|---|---|---|---|---|---|---|---|---|---|---|---|---|---|---|---|---|---|---|---|---|---|---|---|---|
| Localization | WT1 | WT2 | WT3 | RAP60 | RAP140 | RAP220 | RAP300 | RAP380 | RAP460 | RAP540 | RAP620 | RAP700 | HU80 | HU120 | HU160 | rpd3Δ_1 | rpd3Δ_2 | rpd3Δ_3 | WT1 | WT2 | WT3 | AF100 | AF140 | AF180 |
| Cortical Patches | 0 | 0 | 0 | – | 0 | 0 | – | 0 | 0 | 0 | 2 | 0 | 0 | 0 | 0 | 0 | 0 | 0 | 3 | 1 | 3 | 0 | 3 | 1 |
| Bud | 1 | 0 | 0 | – | 0 | 1 | – | 4 | 1 | 8 | 9 | 8 | 0 | 1 | 1 | 0 | 0 | 1 | 3 | 1 | 1 | 0 | 7 | 2 |
| Bud Neck | 1 | 0 | 3 | – | 0 | 0 | – | 3 | 0 | 1 | 0 | 0 | 0 | 0 | 0 | 0 | 1 | 3 | 1 | 0 | 0 | 0 | 3 | 4 |
| Bud Site | 0 | 0 | 0 | – | 0 | 0 | – | 1 | 0 | 0 | 3 | 2 | 0 | 0 | 0 | 0 | 0 | 0 | – | – | – | – | – | – |
| Cell Periphery | 1 | 0 | 2 | – | 0 | 0 | – | 2 | 1 | 1 | 2 | 2 | 0 | 1 | 0 | 6 | 3 | 10 | 0 | 0 | 2 | 0 | 2 | 1 |
| Cytoplasm | 306 | 106 | 71 | – | 16 | 122 | – | 119 | 108 | 143 | 97 | 113 | 264 | 178 | 191 | 260 | 266 | 343 | 281 | 107 | 45 | 109 | 276 | 180 |
| Endoplasmic Reticulum | 2 | 1 | 1 | – | 0 | 0 | – | 0 | 0 | 0 | 0 | 0 | 1 | 1 | 2 | 16 | 27 | 25 | 0 | 0 | 1 | 1 | 0 | 0 |
| Endosome | 1 | 0 | 0 | – | 1 | 0 | – | 0 | 0 | 0 | 0 | 0 | 0 | 0 | 0 | 1 | 2 | 4 | 4 | 0 | 1 | 2 | 2 | 3 |
| Golgi | 0 | 0 | 0 | – | 0 | 0 | – | 0 | 0 | 0 | 0 | 0 | 0 | 0 | 0 | 0 | 1 | 3 | 0 | 1 | 0 | 2 | 2 | 0 |
| Mitochondria | 15 | 6 | 3 | – | 0 | 71 | – | 89 | 134 | 112 | 129 | 132 | 1 | 2 | 1 | 6 | 11 | 12 | 15 | 3 | 21 | 11 | 18 | 11 |
| Nucleus | 0 | 0 | 0 | – | 0 | 0 | – | 2 | 1 | 2 | 0 | 1 | 0 | 3 | 0 | 1 | 2 | 0 | 0 | 0 | 0 | 0 | 0 | 0 |
| Nuclear Periphery | 0 | 1 | 0 | – | 0 | 0 | – | 0 | 0 | 0 | 0 | 0 | 0 | 0 | 1 | 0 | 0 | 0 | 0 | 0 | 0 | 0 | 1 | 0 |
| Nucleolus | 0 | 1 | 0 | – | 0 | 0 | – | 0 | 0 | 0 | 0 | 1 | 0 | 0 | 0 | 1 | 0 | 1 | 0 | 0 | 0 | 0 | 0 | 0 |
| Peroxisomes | 0 | 0 | 0 | – | 0 | 0 | – | 0 | 0 | 0 | 0 | 0 | 0 | 1 | 0 | 3 | 0 | 2 | 1 | 0 | 0 | 0 | 0 | 0 |
| SpindlePole | 0 | 0 | 0 | – | 0 | 1 | – | 2 | 1 | 3 | 2 | 14 | 0 | 1 | 0 | 3 | 0 | 0 | 4 | 1 | 0 | 0 | 6 | 2 |
| Vac/Vac Membrane | 1 | 0 | 0 | – | 0 | 1 | – | 0 | 1 | 2 | 1 | 0 | 0 | 0 | 0 | 4 | 7 | 8 | 3 | 2 | 2 | 3 | 3 | 8 |
| Unique Cell Count | 313 | 109 | 73 | 17 | 152 | 168 | 185 | 207 | 190 | 208 | 266 | 181 | 194 | 274 | 280 | 366 | 325 | 122 | 87 | 143 | 332 | 220 | ||
| Labelled Cell Count | 328 | 115 | 80 | 17 | 196 | 222 | 247 | 272 | 245 | 273 | 266 | 188 | 196 | 301 | 320 | 412 | 325 | 122 | 87 | 143 | 332 | 220 | ||
Yeast GFP Assignment
Protein Abundance
| Screen | WT1 | WT2 | WT3 | RAP60 | RAP140 | RAP220 | RAP300 | RAP380 | RAP460 | RAP540 | RAP620 | RAP700 | HU80 | HU120 | HU160 | rpd3Δ_1 | rpd3Δ_2 | rpd3Δ_3 | AF100 | AF140 | AF180 |
|---|---|---|---|---|---|---|---|---|---|---|---|---|---|---|---|---|---|---|---|---|---|
| Mean Cell GFP Intensity (1e-4) | 3.4 | 3.8 | 3.7 | – | 4.0 | 3.1 | – | 2.8 | 2.4 | 2.7 | 2.4 | 2.4 | 4.3 | 4.4 | 4.5 | 5.7 | 5.2 | 5.6 | 4.4 | 4.4 | 4.4 |
| Std Deviation (1e-4) | 0.6 | 0.9 | 2.7 | – | 2.0 | 2.2 | – | 0.8 | 0.8 | 1.1 | 0.9 | 0.4 | 1.1 | 1.4 | 1.8 | 2.1 | 1.7 | 2.2 | 2.2 | 1.6 | 1.6 |
| Intensity Change (Log2) | – | – | – | – | 0.1 | -0.29 | – | -0.43 | -0.67 | -0.5 | -0.63 | -0.65 | 0.19 | 0.23 | 0.26 | 0.61 | 0.46 | 0.58 | 0.24 | 0.24 | 0.25 |
Localization Change
| Localization | RAP60 | RAP140 | RAP220 | RAP300 | RAP380 | RAP460 | RAP540 | RAP620 | RAP700 | HU80 | HU120 | HU160 | rpd3Δ_1 | rpd3Δ_2 | rpd3Δ_3 |
|---|---|---|---|---|---|---|---|---|---|---|---|---|---|---|---|
| Actin | – | – | – | – | – | – | – | – | – | – | – | – | – | – | – |
| Bud | – | – | – | – | – | – | – | – | – | – | – | – | – | – | – |
| Bud Neck | – | – | – | – | – | – | – | – | – | – | – | – | – | – | – |
| Bud Site | – | – | – | – | – | – | – | – | – | – | – | – | – | – | – |
| Cell Periphery | – | – | – | – | – | – | – | – | – | – | – | – | – | – | – |
| Cyto | – | – | – | – | – | – | – | – | – | – | – | – | – | – | – |
| Endoplasmic Reticulum | – | – | – | – | – | – | – | – | – | – | – | – | – | – | – |
| Endosome | – | – | – | – | – | – | – | – | – | – | – | – | – | – | – |
| Golgi | – | – | – | – | – | – | – | – | – | – | – | – | – | – | – |
| Mitochondria | – | – | – | – | – | – | – | – | – | – | – | – | – | – | – |
| Nuclear Periphery | – | – | – | – | – | – | – | – | – | – | – | – | – | – | – |
| Nuc | – | – | – | – | – | – | – | – | – | – | – | – | – | – | – |
| Nucleolus | – | – | – | – | – | – | – | – | – | – | – | – | – | – | – |
| Peroxisomes | – | – | – | – | – | – | – | – | – | – | – | – | – | – | – |
| SpindlePole | – | – | – | – | – | – | – | – | – | – | – | – | – | – | – |
| Vac | – | – | – | – | – | – | – | – | – | – | – | – | – | – | – |
| Cortical Patches | – | – | – | – | – | – | – | – | – | – | – | – | – | – | – |
| Cytoplasm | – | – | – | – | – | – | – | – | – | – | – | – | – | – | – |
| Nucleus | – | – | – | – | – | – | – | – | – | – | – | – | – | – | – |
| Vacuole | – | – | – | – | – | – | – | – | – | – | – | – | – | – | – |
External localization resources
Images






























Protein Concentration and Protein Localization Data
| R1 | R2 | R3 | ||||||||||||||||
|---|---|---|---|---|---|---|---|---|---|---|---|---|---|---|---|---|---|---|
| G1 Pre-START | G1 Post-START | S/G2 | Metaphase | Anaphase | Telophase | G1 Pre-START | G1 Post-START | S/G2 | Metaphase | Anaphase | Telophase | G1 Pre-START | G1 Post-START | S/G2 | Metaphase | Anaphase | Telophase | |
| Concentration | -0.9804 | -0.662 | -0.9029 | -1.091 | -0.3673 | -0.787 | -0.7595 | -1.1772 | -1.1222 | -1.2946 | -1.1236 | -1.1067 | 0.7965 | -0.1002 | 0.2331 | 0.0994 | 1.3691 | 0.1239 |
| Actin | 0.0092 | 0.0003 | 0.0095 | 0.0103 | 0.0092 | 0.0004 | 0.0534 | 0.0002 | 0.0007 | 0.0002 | 0.0004 | 0.0101 | 0.0081 | 0.0006 | 0.0041 | 0.003 | 0.0009 | 0 |
| Bud | 0.0003 | 0.003 | 0.001 | 0.0001 | 0.0006 | 0.0009 | 0.0012 | 0.0041 | 0.0012 | 0.0069 | 0.0001 | 0.0004 | 0.0373 | 0.0072 | 0.0009 | 0 | 0.0003 | 0 |
| Bud Neck | 0.0003 | 0.0009 | 0.0002 | 0.0014 | 0.0016 | 0.0002 | 0.0048 | 0.0003 | 0.0001 | 0 | 0.0001 | 0.0006 | 0.0059 | 0.0001 | 0.0002 | 0 | 0.0045 | 0 |
| Bud Periphery | 0.0006 | 0.0031 | 0.0016 | 0.0001 | 0.0014 | 0.0004 | 0.0016 | 0.0012 | 0.0004 | 0.005 | 0.0002 | 0.0004 | 0.0134 | 0.0067 | 0.001 | 0 | 0.0004 | 0 |
| Bud Site | 0.0006 | 0.0064 | 0.002 | 0.0007 | 0.0047 | 0.0001 | 0.0088 | 0.0115 | 0.0012 | 0.0004 | 0.0001 | 0.0014 | 0.0254 | 0.0029 | 0.0063 | 0.0001 | 0.0078 | 0 |
| Cell Periphery | 0.0004 | 0.0004 | 0.0001 | 0.0001 | 0.001 | 0.0001 | 0.0004 | 0.0003 | 0.0001 | 0.0001 | 0.0001 | 0.0001 | 0.0009 | 0.0002 | 0.0001 | 0 | 0.0003 | 0 |
| Cytoplasm | 0.0115 | 0.05 | 0.035 | 0.0158 | 0.0203 | 0.0633 | 0.0197 | 0.0184 | 0.0234 | 0.0191 | 0.0227 | 0.0358 | 0.0142 | 0.0224 | 0.0231 | 0.0717 | 0.0087 | 0.0372 |
| Cytoplasmic Foci | 0.0059 | 0.016 | 0.0161 | 0.0038 | 0.0375 | 0.0044 | 0.0335 | 0.0033 | 0.0044 | 0.003 | 0.0034 | 0.0107 | 0.0668 | 0.0015 | 0.014 | 0.0058 | 0.0647 | 0.0165 |
| Eisosomes | 0.0007 | 0.0002 | 0.0003 | 0.0002 | 0.0004 | 0.0001 | 0.0005 | 0.0005 | 0.0002 | 0.0001 | 0.0001 | 0.0001 | 0.0003 | 0.0002 | 0.0002 | 0.0001 | 0.0001 | 0 |
| Endoplasmic Reticulum | 0.001 | 0.0009 | 0.0009 | 0.0002 | 0.0075 | 0.0008 | 0.0019 | 0.0003 | 0.0014 | 0.0004 | 0.0043 | 0.0003 | 0.0018 | 0.0008 | 0.0007 | 0.0153 | 0.0002 | 0.0004 |
| Endosome | 0.0057 | 0.0044 | 0.0033 | 0.0011 | 0.0362 | 0.0039 | 0.018 | 0.0002 | 0.006 | 0.0004 | 0.0108 | 0.0048 | 0.0285 | 0.0001 | 0.0103 | 0.0059 | 0.038 | 0.0151 |
| Golgi | 0.0011 | 0.0003 | 0.0021 | 0.0032 | 0.0363 | 0.0006 | 0.0091 | 0 | 0.0016 | 0 | 0.0006 | 0.0035 | 0.01 | 0 | 0.0029 | 0.0016 | 0.0276 | 0.0004 |
| Lipid Particles | 0.0074 | 0.0018 | 0.0034 | 0.0061 | 0.0219 | 0.0002 | 0.0168 | 0.0003 | 0.0007 | 0.0002 | 0.0004 | 0.0064 | 0.0361 | 0.0001 | 0.0047 | 0.0005 | 0.0788 | 0.0001 |
| Mitochondria | 0.0062 | 0.0039 | 0.0059 | 0.018 | 0.0445 | 0.0019 | 0.0082 | 0.0005 | 0.0011 | 0.0011 | 0.0017 | 0.0009 | 0.0308 | 0.0007 | 0.0042 | 0.0002 | 0.1172 | 0.0001 |
| None | 0.9203 | 0.8873 | 0.9084 | 0.9215 | 0.7211 | 0.9149 | 0.7888 | 0.9515 | 0.9335 | 0.9092 | 0.8402 | 0.9078 | 0.6334 | 0.9522 | 0.9192 | 0.894 | 0.5909 | 0.9292 |
| Nuclear Periphery | 0.0064 | 0.0011 | 0.0005 | 0.0001 | 0.009 | 0.0003 | 0.0025 | 0.0004 | 0.0014 | 0.0008 | 0.0305 | 0.0003 | 0.0011 | 0.0004 | 0.001 | 0.0006 | 0.0001 | 0.0001 |
| Nucleolus | 0.0089 | 0.0025 | 0.0002 | 0.0001 | 0.0021 | 0.0002 | 0.0008 | 0.0016 | 0.0009 | 0.0018 | 0.0011 | 0.0005 | 0.0026 | 0.0003 | 0.0006 | 0 | 0.0113 | 0 |
| Nucleus | 0.0042 | 0.0024 | 0.0004 | 0.0003 | 0.0078 | 0.0009 | 0.0046 | 0.0025 | 0.0097 | 0.0479 | 0.071 | 0.001 | 0.0018 | 0.0006 | 0.0007 | 0.0002 | 0.001 | 0.0001 |
| Peroxisomes | 0.002 | 0.0032 | 0.0069 | 0.0161 | 0.0185 | 0.0001 | 0.0187 | 0.0001 | 0.0076 | 0.0002 | 0.0001 | 0.0066 | 0.0703 | 0.0001 | 0.0026 | 0.0001 | 0.0391 | 0.0001 |
| Punctate Nuclear | 0.0039 | 0.0021 | 0.0007 | 0.0005 | 0.0129 | 0.0009 | 0.0034 | 0.0021 | 0.0033 | 0.0024 | 0.0004 | 0.0076 | 0.0085 | 0.0026 | 0.0016 | 0.0002 | 0.0038 | 0.0001 |
| Vacuole | 0.0023 | 0.0087 | 0.0011 | 0.0002 | 0.0035 | 0.0034 | 0.0024 | 0.0005 | 0.0008 | 0.0004 | 0.0061 | 0.0005 | 0.0022 | 0.0002 | 0.0013 | 0.0003 | 0.0033 | 0.0004 |
| Vacuole Periphery | 0.0008 | 0.0014 | 0.0004 | 0.0001 | 0.0018 | 0.002 | 0.0009 | 0.0001 | 0.0002 | 0.0002 | 0.0056 | 0.0001 | 0.0005 | 0 | 0.0003 | 0.0001 | 0.0012 | 0.0001 |
Sequencing Data
| R1 | R2 | |||||||||
|---|---|---|---|---|---|---|---|---|---|---|
| G1 Post-START | S/G2 | Metaphase | Anaphase | Telophase | G1 Post-START | S/G2 | Metaphase | Anaphase | Telophase | |
| Gene Expression | 33.332 | 53.4287 | 28.9724 | 38.9296 | 50.6675 | 22.9749 | 43.6329 | 45.5763 | 36.6007 | 38.4973 |
| Translational Efficiency | 1.805 | 1.7304 | 2.0223 | 1.5162 | 1.1763 | 2.1288 | 1.8063 | 1.698 | 1.635 | 1.4213 |
Hit Data
| Dataset | Hit |
|---|---|
| Protein Concentration | ✔ |
| Protein Localization | ✘ |
| Gene Expression | ✘ |
| Translational Efficiency | ✘ |
Endocytosis
| Temp | Actin Patch (Sac6-tdTomato) | Cortical Patch (Sla1-GFP) | Late Endosome (Snf7-GFP) | Vacuole (Vph1-GFP) |
|---|---|---|---|---|
| 37℃ | ||||
| RT |
Cell Cycle Omics
CYCLoPs (Gna1-GFP)
| Gene / Allele | Actin Patch (Sac6-tdTomato) | Cortical Patch (Sla1-GFP) | Late Endosome (Snf7-GFP) | Vacuole (Sac6-tdTomato) |
|---|
| Gene | Images |
|---|
| Gene | Images |
|---|
Images are not yet available
Images are not yet available